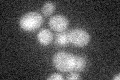
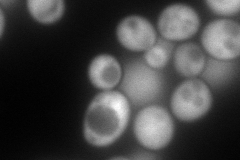
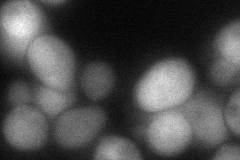
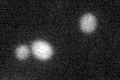

View description
Metallothionein, binds copper and mediates resistance to high concentrations of copper and cadmium; locus is variably amplified in different strains, with two copies, CUP1-1 and CUP1-2, in the genomic sequence reference strain S288C
Localization:
Intensity:
Fold change:
Significance:
-
C’ GFP library in SD
below threshold14.79 -
N' NOP1pr-GFP in SD
cytosol194.996 -
N' TEF2pr-mCherry in SD

missing0 -
N' NATIVEpr-GFP in SD

below threshold18.0686 -
N' TEF2pr-VC and Cyto-VN in SD
cytosol75.3416 -
C’ GFP library in SD+DTT
cytosol17.31.16No -
C’ GFP library in SD+H2O2

cytosol15.941.07No -
C’ GFP library in Starvation Media

cytosol15.591.05No -
C’ GFP library on the background of Pup2-DaMP

below threshold -
C’ GFP library on the background of CCT mutant

below threshold13.54420.914949No
